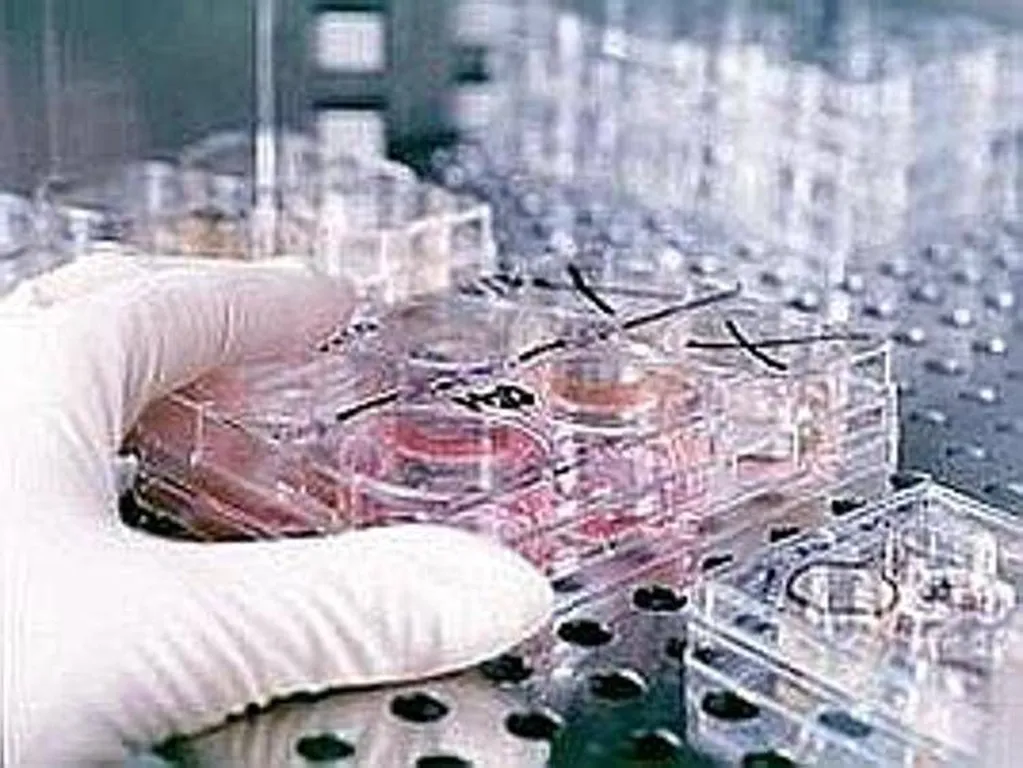

Si chiama adenomiosi ed è una malattia 'sorella' dell'endometriosi. Mestruazioni abbondanti, dolori pelvici e difficoltà nel concepire un bimbo sono tra i segni di questa condizione ginecologica benigna, che però complica la vita alle aspiranti mamme anche quando si rivolgono ai centri di fecondazione assistita. C'è infatti l'adenomiosi tra le cause principali di fallimento dell'impianto embrionale e di aborto spontaneo dopo una procedura di Pma. Una patologia tutt'altro che rara: colpisce milioni di donne, fino a 1 su 5 in età fertile. Ma "non è una condanna". Un nuovo protocollo ormonale targato Ivi, tra i principali gruppi internazionali nel campo della riproduzione medicalmente assistita, promette di spegnere l''incendio' che alimenta l'adenomiosi e, "per la prima volta", di raddoppiare le chance di gravidanza rispetto ai trattamenti standard. L'approccio è fra le novità del 41esimo Congresso annuale della Società europea di riproduzione umana ed embriologia (Eshre 2025 - Parigi, 29 giugno-2 luglio).
Le pazienti con adenomiosi presentano tessuto endometriale, quello che normalmente riveste internamente l'utero, dentro al miometrio, lo strato muscolare uterino. Così la parete dell'utero si ispessisce e si sviluppano i sintomi. "Adenomiosi ed endometriosi sono malattie sorelle, condividono una base genetica e infiammatoria comune: tutto parte da una mutazione dell'oncogene K-ras, che altera l'endometrio rendendolo resistente al progesterone", descrive Mauro Cozzolino, specialista in medicina della riproduzione e direttore del Centro Ivi di Bologna, che ha guidato lo studio illustrato al meeting. "L'adenomiosi è caratterizzata da un eccesso di estrogeni e da uno stato infiammatorio cronico che compromettono la recettività dell'endometrio". Con il nuovo protocollo, sottolinea l'esperto, "riusciamo a spegnere il fuoco ormonale che alimenta la malattia e a migliorare significativamente gli esiti nei trattamenti di fecondazione assistita". La strategia si basa sul mix tra un GnRH agonista e un inibitore dell'aromatasi, somministrati prima del transfer embrionario. "Questa combinazione funziona perché agisce sulle radici biologiche della malattia", spiega Cozzolino.
Lo studio è stato condotto presso Ivi Roma su donne tra i 30 e i 49 anni con una forma di adenomiosi chiamata adenomioma, analizzando trasferimenti di embrioni congelati. Le pazienti che hanno seguito lo specifico trattamento ormonale - 2 mesi di un farmaco che blocca la produzione degli estrogeni da parte delle ovaie, seguiti da 3 settimane di un altro farmaco che riduce l'effetto degli estrogeni presenti nei tessuti dell'utero - hanno ottenuto quasi il doppio delle gravidanze rispetto a chi ha ricevuto il trattamento standard: 47% contro 26%, riferisce Ivi. Doppio anche il numero di gravidanze confermate ecograficamente: 66% nel gruppo trattato, rispetto al 33% nel gruppo di controllo. "Sono risultati molto significativi - commenta il Cozzolino - e segnano un importante passo avanti nel trattamento di una condizione spesso sottovalutata".
Il protocollo Ivi "abbassa l'infiammazione, riduce le contrazioni dell'utero e migliora le condizioni per accogliere l'embrione. Ci sono anche indizi che suggeriscono un altro beneficio importante", rimarca il gruppo: "Questo trattamento sembra aumentare la presenza di alcune molecole, chiamate integrine, che aiutano l'embrione ad 'attaccarsi' meglio all'endometrio". Contribuendo dunque al successo dell'impianto e della gravidanza. "Anche tenendo conto di fattori come l'età della paziente, il peso, la qualità degli embrioni e lo stato dell'endometrio - precisa Ivi - il trattamento ha continuato a dimostrare la sua efficacia".
"Il nostro approccio permette di ridurre il rischio di aborti e aumentare il numero di bambini nati - afferma Cozzolino - Per noi questo protocollo è già lo standard nei casi di adenomiosi: non eseguiamo transfer senza questo pretrattamento. Ora il prossimo passo è uno studio multicentrico e randomizzato che stiamo costruendo insieme ad altri gruppi europei", prospetta lo specialista lanciando un messaggio di speranza alle pazienti: "L'adenomiosi non è una condanna. Con i giusti trattamenti è possibile ottenere una gravidanza, anche se potrebbe servire più di un tentativo o il trasferimento di più embrioni. Il punto è non arrendersi".
Cruciale, a monte, riconoscere la malattia per tempo. "La diagnosi di adenomiosi è sempre stata difficile - osserva Cozzolino - perché si basava solo su conferme istologiche dopo isterectomia. Oggi, grazie all'ecografia esperta, possiamo diagnosticare in modo non invasivo, ma servono competenze specifiche: una donna con dolori mestruali persistenti o sanguinamenti anomali deve essere valutata da un ginecologo esperto in ecografia, perché molti casi vengono ancora ignorati o sottovalutati". Da qui la raccomandazione ai colleghi: "Una donna con dolori mestruali ricorrenti non va liquidata con un antidolorifico. Serve un'ecografia fatta bene, da un professionista che sa riconoscere questa condizione. La diagnosi precoce può cambiare tutto".